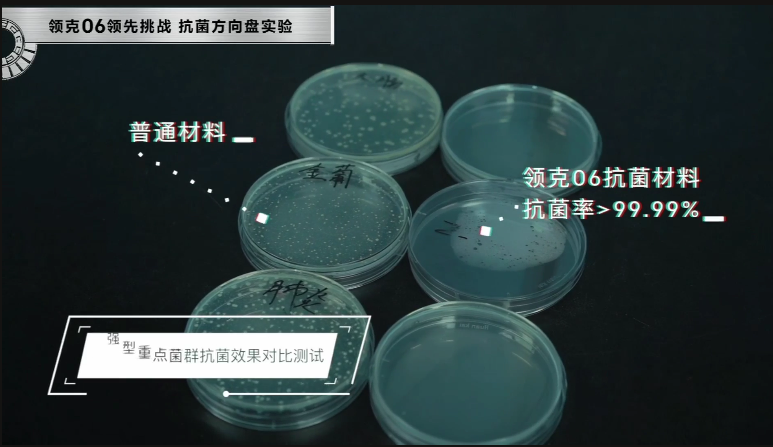

个人信息不会泄露给第三方
近年来中国汽车的安全技术飞速发展,高刚性车身、吸能车身等技术遍地开花,但是目前行业内对于什么样的一款车才算的上安全还没有一个明确的定义,7月5日,领克汽车携旗下全新紧凑型SUV——领克06 (配置|询价)在天津、广州、上海三地联动,举办了“领克06三大安全黑科技全球首测”线上活动,在直播中为我们展示了领克06强大的安全属性,树立了“同级更安全的机能SUV”新标签。

测试一:领克06领先挑战临界翻滚保护测试
车辆发生翻滚事故,车内成员就如同精美包装盒里的玻璃杯一样脆弱,包装盒内的发泡填充保护物就好比是气囊,时刻保护着脆弱的玻璃杯,汽车气囊不可能处于永久弹开状态,所以气囊在什么条件下打开、打开后要持续保压多久等一系列被动保护逻辑需要一个公认的行业标准,这就是领克06挑战临界翻滚保护测试的初衷所在。

据中国最大的深度事故数据库CIDAS显示,在造成乘用车内人员伤亡的事故中,涉及翻滚的事故比例达到17.2%,正面碰撞、侧面碰撞这类常见事故形态是同一量级。从伤亡严重度上看,翻滚事故受伤率55.6%,死亡率10.9%,远高于正面、侧面、追尾等。在事故道路环境中,62.4%的乘用车翻滚事故发生在平直道路上。而感觉上更容易造成车辆翻滚的弯道,占比只有12.9%。在受伤部位统计中,头部受伤的几率高达40%以上,严重时甚至可能会危及生命。

为保障用户的安全,领克06在翻滚方面配备了“防护安全双保险”。首先在“防”方面,领克06搭载了博世9.3ESP车辆稳定控制系统,本身就对车辆侧翻有主动预防措施,更不容易发生侧翻,而在不可避免的情况下,领克06配备了RP(Rollover Protection)翻滚保护系统,能够在侧翻的情况下保证防护功能能够及时启动,发挥出“护”的功能,值得一提的是,克06的RP(Rollover Protection)翻滚保护系统针对中国道路、事故状况进行设计开发,是中国首款翻滚保护系统,也是中国品牌首次量产搭载。

在这次中国首次公开翻滚保护系统实车测试中,领克06获得了9项全优秀的成绩,测试结果显示,领克06在翻滚测试中侧气帘在触地点前点爆、翻滚过程中车门无开启情况,同时车辆的A柱、B柱均没有发生结构性失效,而在试验过后,4个车门均可正常打开,且F-CALL紧急通话系统也可以正常启动。

据了解,领克汽车基于全球最全翻滚保护矩阵典型工况,翻滚保护系统进行了螺旋翻滚、边坡翻滚、沙坑侧翻、路阶侧翻4大类型翻滚工况模拟。并结合中国道路交通事故调研,基于大数据进行13项翻滚路况模拟测试。同时,通过多次模拟与全车承载成年男性/成年女性、无儿童座椅保护未成年人伤害考察和气囊参数匹配。从2016年开始,历经40多次的实车翻滚测试,模拟测试时间累计超过15000小时。

于此同时,领克06独特的气囊设计,可实现34L同级超大容积侧气帘和超长6S保压时间。配合上国际超高灵敏度翻滚传感器配合全新翻滚保护算法,在凌空翻滚临界点智能触发气囊,而非在汽车翻滚着地时打开,及时开启乘员保护。此外,当安全气囊弹出时,领克06会自动收集车况信息(碰撞速度、行驶方向等)和定位信息(GPS坐标),并在第一时间将以上信息发送至后台,后台会第一时间与客户建立语音通话。

另外,领克还采用了同级独有的笼式高强度五星安全车身,并拥有独创的11项车身专利设计,首先在用料方面,领克06车身打造中糅合多种类型的高强度钢材,其中高强度钢、超高强度钢和PHS钢材(热成型钢)占比高达63.4%,大于1mm厚的钢材占比超过61.1%,大于2mm厚的钢材占比超过8.4%,其中车身15.76%的部位采用热成型钢,其最高抗拉强度达到1600MPa,造就满足美标IIHS的“刚毅”属性。
同时领克06的车身钢材还应用较多镀层板,经过海南模拟10年防腐试验的严格检验,超高车身钢材镀层比塑造“钢铁皮肤”,并针对车身底部腔体进行了总共36处的高精准注蜡约1KG,作为增强防护涂层加强耐腐蚀性。大大提高车身寿命,亦能有效降低养护压力。

目前,中国汽车行业尚缺乏翻滚防护的法规或标准,领克是国内首个进行翻滚矩阵试验的汽车品牌,也将是国内对翻滚保护研究最全面的汽车品牌。此次测试是中国首测翻滚保护系统实车测试,填补了行业空白,为推动中国汽车安全标准升级起到了典范作用。
测试二:领克06领鲜挑战深林五重空气净化实验
2013年10月17日,世界卫生组织(WHO)下属国际癌症研究机构发布报告,首次指认大气污染对人类致癌,并视其为普遍和主要的环境致癌物。研究指出,对颗粒的长期暴露可引发心血管病和呼吸道疾病以及肺癌。当空气中PM2.5的浓度长期高于10ug/m^3,就会带来死亡风险的上升。此外,PM2.5极易吸附多环芳烃等有机污染物和重金属,使致癌、致畸、致突变的机率明显升高。而在疫情发生之后,汽车出行和车内空气质量成为了大家关心的问题。

为此,领克特别推出了林五重空气智能净化系统,该系统通过整合一键远程车窗透气、主动式座舱清洁系统、AQS空气质量管理系统、PM2.5/CN95级滤芯、负离子发生器,实现了“透、换、挡、阻、除”的空气净化的生态。同时该系统还具备智能唤醒自主净化功能,可主动判定车外空气质量,保持车内空气时刻处于最佳状态;集成多个空气清洁模块,形成优势互补、功能联动、效力协同的系统性空气净化生态链,高效、高品净化座舱空气;融入智能网联技术,支持移动端APP远程遥控操作,实现“用车周期全净化”。

而在疫情之下,领克06的“车规级CN95”高效复合空调滤芯,曾获得中国汽车技术研发中心(简称“中汽研”)华城认证中心颁发的“CATARC CN95”认证标志,是国内首款(001号认证)获中汽研官方最高级别认证的车载空调滤芯产品,具有去除PM2.5、防霉、除异味、杀菌、除甲醛、抗过敏等功能,对直径0.3μm的颗粒过滤效率达到95%以上,达到“N95”型口罩级别的防护效果,并可过滤空气中的细菌、病毒、过敏原等,杀死95%以上的大肠杆菌及99%的黄金色葡萄球菌,对新冠病毒吸附的0.74μm飞沫过滤效率达到98%,对新型冠状病毒起到有效的隔离作用。
测试三:领克06领先挑战抗菌方向盘实验
国际生物研究中心(NCBI)调查显示,汽车内饰非常容易“藏污纳垢”,尤其是驾驶者每天都要接触的方向盘。在极限测试情况下,每cm²会有800种细菌。按照菌落形成单位CFU来计算,汽车方向盘的细菌量高达629CFU,比公共厕所马桶座的172CFU,高出4倍有余。
日常用车生活中易接触到几十种致病细菌,包括大肠杆菌、金黄色葡萄球菌、沙门氏菌、肺炎链球菌、溶血链球菌在内,这些病菌长时间存在于车辆内会引发呼吸道、胃肠道疾病、皮肤病甚至是肺炎、败血症等,对驾驶员的身体健康造成严重威胁。

为此,领克06推出了抗菌方向盘,同时领克06也是首款款搭载抗菌方向盘的领克车型,经过试验证明,领克06抗菌方向盘采用无机抗菌剂,兼具有机系的即效性、持续性与无机系的安全性、耐热性,对大肠杆菌、金黄色葡萄球菌、霉菌等生活中常见的细菌均有抑制作用。通过对细菌表面的蛋白质进行变性破坏,阻止其嵌入人体细胞,从而达到抗菌作用。具有高效的抑制、杀菌、防霉功能,实现方向盘自清洁,抗菌率高达99.9%。
写在最后
秉承领克品牌“全域安全”理念,领克06在安全方面不断进阶,此次“三大安全黑科技全球首测”活动全面展示了领克06从用户实际用车需求出发,向更高安全标准进阶,以内外兼修的硬核机能实力,为用户提供更全面安全防护的初衷,也为领克06塑造了“同级更安全的机能SUV”新标签。
本文转自:有车CLUB